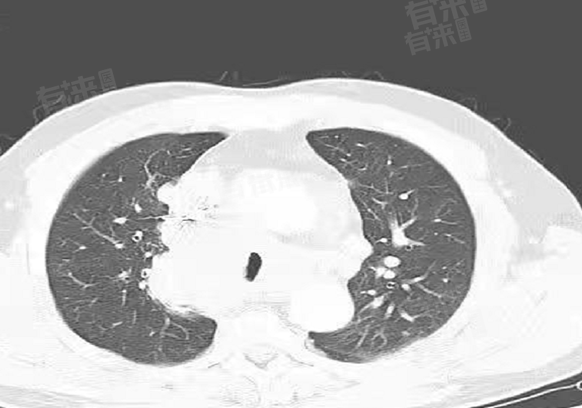

“早期肺CA”指的是早期肺癌,其中“CA”是英文“Cancer”(癌症)的缩写,在医学领域常被用于简化书写、保护患者隐私。早期肺癌通常指肿瘤局限于肺部,尚未发生区域淋巴结转移和远处转移,肿瘤大小、侵犯范围符合特定标准,如肿瘤直径较小,未累及重要结构。
- 从病理角度,早期肺CA癌细胞仅在肺组织内局部生长,未突破基底膜向周围组织浸润扩散,或仅有极少量细胞开始突破基底膜但仍局限在较小范围。这使得肿瘤边界相对清晰,未与周围正常肺组织发生广泛粘连,为手术切除提供了较好的条件。
- 肿瘤的生长具有一定规律,早期肺CA阶段,肿瘤细胞数量相对较少,倍增速度还未达到快速进展期。肿瘤对周围肺组织的压迫和破坏较轻,尚未引发明显的全身性症状,也未刺激机体产生强烈的免疫反应,因此患者多无典型临床表现,常通过体检发现。
- 在影像学表现上,早期肺CA在胸部CT等检查中,可能呈现为小结节、磨玻璃影等特征,边界相对规整,与周围血管、支气管等结构关系不密切。这种相对清晰的影像特征有助于医生判断肿瘤的位置、大小,从而制定治疗方案。
从治疗角度看,早期肺CA因肿瘤的局限性,治疗手段选择相对较多且效果较好。通过手术完整切除肿瘤病灶,能够有效清除癌细胞,术后患者五年生存率较高,部分患者甚至可以达到临床治愈标准,极大改善了患者的预后和生存质量。
早期肺CA患者的护理要点
1、规范治疗管理:确诊早期肺CA后,需积极配合医生制定治疗方案,无论是手术、放疗还是其他治疗方式,都要严格遵循医嘱,按时治疗,不随意更改治疗计划,以确保最佳治疗效果。
2、定期复查监测:治疗结束后,定期前往医院复查胸部CT、肿瘤标志物等项目,及时发现肿瘤是否复发或转移,做到早发现、早干预,同时便于医生根据复查结果调整后续康复方案。
3、生活方式调整:保持健康的生活方式,戒烟戒酒,避免接触二手烟和有害化学物质;均衡饮食,多摄入富含蛋白质、维生素的食物;适度运动,如慢跑、瑜伽,增强体质,助力身体恢复。

